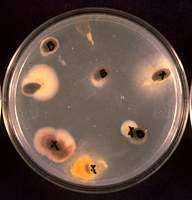

Fusarium wilt of watermelon and other cucurbits
Fusarium oxysporum Schlechtend:Fr. (emend. Snyd. & Hans.) f. sp. niveum (E.F. Sm.), f. sp. melonis (Leach & Curr.), and f. sp. cucumerinum (J.H. Owen)
Watermelon [Citrullus lanatus (Thunb.) Matsum. & Nakai]; Melon (Cucumis melo L.); Cucumber (Cucumis sativus L.)
The Cucurbitaceae plant family is affected by several vascular wilt diseases caused by different formae speciales of the fungus Fusarium oxysporum, which are morphologically similar, but generally host-specific. The most economically important of these attack watermelon, muskmelon, or cucumber. The cucurbit wilt fusaria are similar in terms of their biology, epidemiology and management. Consequently, Fusarium wilt of watermelon, caused by Fusarium oxysporum f. sp. niveum, is described here as an example of the group. Fusarium wilt of watermelon is one of the oldest described Fusarium wilt diseases and the most economically important disease of watermelon worldwide. It occurs on every continent except Antarctica and new races of the pathogen continue to impact production in many areas around the world. Long-term survival of the pathogen in the soil and the evolution of new races make management of Fusarium wilt difficult.

Fusarium wilt of watermelon caused by Fusarium oxysporum f. sp. niveum (Courtesy D.S. Egel) |
Symptoms and Signs
Symptoms of Fusarium wilt are similar on all cucurbits and are dependent on several factors, including the amount of inoculum in the soil, environmental conditions, nutrients (particularly nitrogen), and susceptibility of the host. Fusarium wilt is characterized by loss of turgor pressure of the vines. Vines may recover during the evening, but eventually wilt permanently (Figure 1 and 2). Initial symptoms often include a dull, gray green appearance of leaves that precedes a loss of turgor pressure and wilting. Wilting is followed by a yellowing of the leaves and finally necrosis. The wilting generally starts with the older leaves and progresses to the younger foliage. Initial symptoms often occur as the plant is beginning to vine and wilting may occur in only one runner leaving the rest of the plant apparently unaffected (Figure 1). Under conditions of sufficiently high inoculum density or a very susceptible host, the entire plant may wilt and die within a short time. Affected plants that do not die are often stunted and have considerably reduced yields. Under high inoculum pressure, seedlings may damp off as they emerge from the soil. Zhou and Everts surveyed numerous watermelon fields in Maryland and Delaware to determine the level of F. o. f. sp. niveum present in each field and the subsequent amount of wilt observed in a susceptible cultivar at harvest. They concluded that the minimum amount of inoculum necessary to cause wilt was 166 CFU/g soil and that 367 CFU/g was enough to cause wilt in 50% of the plants (ID50). In most of the fields examined (73%) the CFU/g soil values ranged between 100 and 1,200.

Figure 1 |

Figure 2 |
The primary diagnostic symptom of Fusarium wilt is a discoloration of the vascular system (xylem), which can be observed readily in longitudinal or cross section of roots or stems (Figures 3 and 4). In watermelon and muskmelon, a brown necrotic streak may be visible externally on the lower stem and extending along the length of the vine. Since the pathogen is soilborne, symptomatic plants often occur in clusters corresponding to the distribution of high inoculum densities in the soil. Fusarium wilts are generally most severe in light, sandy, slightly acidic soils when temperatures are between 25 and 27 C. Higher temperatures appear to impede infection often resulting in plants that are yellowed and stunted but not wilted. However, plants infected earlier in the season may display more severe symptoms later in the season, as the temperature increases, and there is more transpiration demand on the plant.

Figure 3 |

Figure 4 |
Watermelon and other cucurbits also are susceptible to a vascular wilt disease caused by the fungus Verticillium dahliae (Verticillium wilt) that may be confused with Fusarium wilt, as the symptoms are very similar. Neither fungus readily sporulates on the surface of the plant and confirmation of the causal agent may require isolation of the pathogen from the diseased plant onto an agar growth medium and subsequent observation under a microscope.
Pathogen Biology
Fusarium oxysporum f. sp. niveum (FON) has no known sexual reproductive stage. Asexual reproductive structures include both micro- and macroconidia (Figures 5 and 6). Microconidia are abundant, oval to kidney-shaped, generally one-celled and are formed on short conidiophores. Microconidia are capable of infecting roots but probably play little role in initial infection in the field because of their ephemeral nature. Macroconidia are fusiform (‘canoe-shaped’), typically having three to five cells (Figures 6 and 7) and are produced in large numbers, often in clumps known as sporodochia. Macroconidia also infect roots, but their primary role may be survival as they have the ability to form chlamydospores (asexual resting structures). Chlamydospores are the primary means of survival and typically form under conditions of suboptimal growth for the fungus or death of the host plant. F. oxysporum forms two types of chlamydospores; one within the macroconidium (Figure 7) and one from within the mycelium. Those formed from mycelia tend to occur singly or in pairs and may be either intercalary (within the mycelium) or terminal (occurring at the ends).

Figure 5 |

Figure 6 |

Figure 7 |
Fusarium oxysporum is a cosmopolitan soilborne fungus with both saprophytic and pathogenic members. Pathogenic strains (formae speciales) are somewhat specialized and are defined on the basis of the host they predominantly infect. Currently, there are over 100 different formae speciales described, causing disease in a wide range of dicot and monocot plant species. Many are further divided into pathological races based on their pathogenicity to a set of differential host cultivars, each with a unique set of resistance genes. Six different formae speciales have been described that cause wilt in curcurbits: F. o. f. sp. niveum (watermelon); F. o. f. sp. melonis (muskmelon); F. o. f. sp. cucumerinum (cucumber) are the most economically important. While there are reports of cross infection between some formae speciales, these are mostly laboratory and greenhouse phenomena and, in the field, the cucurbit wilt fusaria are host-specific and rarely cross-infect. The biology, pathology, epidemiology, and control are very similar among all of the cucurbit-infecting formae speciales.
Ideally, races are described based on their ability to overcome specific resistance genes in a set of differential cultivars (Table 1). Race 0, first detected in Florida in 1963, is pathogenic only on watermelon cultivars with no resistance genes and, therefore, is of little economic importance. Race 1 is the predominant race throughout commercial watermelon regions in the U.S. and world. Thanks to plant breeding programs initiated over a hundred years ago, most commercial diploid cultivars have a high degree of resistance to race 0 and 1. There is growing speculation, however, that the distinction between race 0 and race 1 may be more quantitative than qualitative and, consequently, race 0 and race 1 may all be strains of race 1 varying in aggressiveness. On the other hand, race 2 is highly aggressive to all current commercial watermelon cultivars and hybrids and clearly is a distinct race. A new race (race 3) was recently confirmed from the eastern US that overcomes the resistance in PI296341-FR. Since resistance to race 2 in PI296341-FR is complex and is not fixed, segregation for susceptibility still occurs and extra caution is needed when using this PI line as a differential, since false positives may occur. Alternatively, the watermelon varieties Super Pollinizer-5 (SP-5) (U.S. Patent number 8,173,873 and Super Pollinizer-6 (SP-6) (U.S. Patent number 8,212,118) developed by Syngenta Seeds, Inc. show promise as differentials as the wilt resistance in them was derived from PI-296341-FR .
Vegetative compatibility Groups (VCG) also has been used to differentiate races from each other. Race 2 was differentiated from race 1 by VCG and race 3 was differentiated from races 0, 1 and 2. Race 2 was first observed in Israel in 1973 and now occurs in at least eight U.S. states (Florida, Texas, Oklahoma, Maryland, Delaware, Georgia, South Carolina and Indiana) and at least 12 countries. Triploid (seedless) cultivars are generally more susceptible to all races of Fusarium. No commercial diploid genotypes have high resistance to race 2; however, an improved plant introduction line from South Africa (PI-296341-FR) has high resistance to races 0, 1 and 2, but not 3. Several other PI lines also are reported to have partial resistance to race 2. Because identification to race requires inoculation onto a set of differential watermelon cultivars, other means of identifying races have been investigated, including, isozyme polymorphisms, and various types of DNA markers, but no one method has proven totally reliable.
Table 1: Watermelon genotypes used to differentiate races of
Fusarium oxysporum f. sp. niveum |
| |
Disease response to:a |
|
Cultivar or genotype |
Race 0 |
Race 1 |
Race 2 |
Race 3 |
|
Sugar Baby, Black Diamond |
S |
S |
S |
S |
|
Charleston Gray |
R |
S |
S |
S |
|
Calhoun Gray |
R |
R |
S |
S |
|
PI 296341-FRb |
R |
R |
R |
S |
aS=susceptible. R=resistant.
b Extreme care should be taken when using this PI as a differential, as the resistance is not fixed and seed increases may contain susceptible individuals, resulting in false positives. |
Disease Cycle and Epidemiology
Disease Cycle
The disease cycle for all cucurbit Fusarium wilts is similar. Initial infection of seedlings usually occurs from chlamydospores that have overwintered in the soil. Chlamydospores germinate and produce infection hyphae that penetrate the root cortex, often where the lateral roots emerge. Infection may be enhanced by wounds or damage to the roots. The fungus colonizes the root cortex and soon invades the xylem tissue, where it produces more mycelia and microconidia. Microconidia may be carried in the transpiration stream up the xylem (Figure 8) where they may become lodged against the vessel wall or perforation plate. Subsequent germination results in hyphae that penetrate and emerge on the other side where they repeat the process of mycelial growth and sporulation. Consequently, the fungus becomes systemic and often can be isolated from tissue well away from the roots. Once infection has occurred, FON is limited to the xylem and generally emerges only after death of the plant.

Figure 8 |
In response to the advance of the fungus within the xylem, the host plant typically produces tyloses, in an attempt to restrict pathogen movement. Tyloses are invaginations of the xylem parenchyma cells that grow into the vessels and impede water flow (Figures 9-13), as compared to vessels in healthy plants with no tyloses (Figure 10). If the tyloses form quickly enough and sufficiently to completely plug the xylem vessel, before the fungus has proceeded up the plant, they may prevent systemic colonization of the xylem - the result being a resistant plant. In susceptible plants, however, tyloses form more slowly and do not completely block the vessel (Figures 9 & 11), ultimately allowing the fungus to pass through. As the fungus continues to colonize the xylem, more tyloses are formed, eventually restricting water flow and causing the vine to wilt. The formation of tyloses in some vessels and not in others partially explains the ‘one-sided’ wilt (Figure 1) often seen in watermelon and muskmelon. In addition, the pathogen causes a general breakdown of the xylem parenchyma cells resulting in various types of gums that add to the blockage. The extent to which fungal toxins are involved in pathogenesis is not known. Further colonization of the tissue results in necrosis and cellular gums that hastens wilt and death of the plant and produces the characteristic brown discoloration of the vascular tissue (Figures 3 & 4). Because the fungus is systemic in the xylem, it can be readily isolated from diseased plants by surface-disinfesting cross sections of the stem or root and plating them onto a growth medium. Mycelium of F. oxysporum will emerge directly from within the xylem within 24 - 48 hours (Figures 14 and 15).

Figure 9 |

Figure 10 |

Figure 11 |

Figure 12 |

Figure 13 |

Figure 14 |

Figure 15 |
The vascular wilt fusaria spend most of their time within the plant. In the very late stages of disease or upon plant death, the fungus begins to grow profusely along the outside of the decayed stem, producing thick mats of white mycelia (Figure 16) and abundant macroconidia. Macroconidia become incorporated into the soil and, along with the mycelium, convert into chlamydospores, which can remain dormant until next season. Chlamydospores formed within the mycelium may survive in a dormant state in the soil for 15 to 20 years.

Figure 16 |
Epidemiology
Fusarium wilts are generally presumed to be monocyclic - that is, the disease does not exhibit plant-to-plant spread during the season. This is primarily because there are no propagules capable of dissemination to other plants to cause secondary infections that form above ground until very late in the season. However, the time to appearance of symptoms and the rate of disease progression in plants may vary considerably within a field, giving the appearance of secondary spread. There is some evidence that suggests some Fusarium wilts, i.e., Fusarium wilt of tomato, in fact, may be a polycyclic disease capable of significant secondary spread during the season. While the extent of secondary plant-to-plant spread of Fusarium wilt of watermelon is not entirely clear, the pathogen can be spread within a field over a period of several seasons and from field to field. Spread within a field can occur by the movement of infested soil. Tillage practices, flooding or heavy rain, contaminated farm equipment, and other cultural or environmental factors may be involved. Field-to-field spread can occur when equipment and infected plants are moved from one field to another. It is possible that macroconidia formed on the decaying vines on the soil surface could be blown short distances and aid in the spread. Watermelons typically are grown using commercially produced transplants, and shipment of infected transplants is likely responsible for most long distance spread.
Many Fusarium wilt pathogens, including F. oxysporum f. sp. niveum, are capable of being seedborne, although the extent of the contamination varies widely. There is little direct evidence as to how the seed becomes infected and/or contaminated but the likely means are either by direct infection of the developing seed by the fungus within the infected plant or by accidental contamination of the seed during harvesting and seed extraction. F. oxysporum f. sp. niveum has been isolated from both the external seed coat (Figures 17-19) and from within the seed (Figures 20 & 21). The role of contaminated seed in the long distance dissemination of Fusarium wilt of watermelon is not entirely known, as seed contamination has been documented only sporadically.
Figure 17 |

Figure 18 |

Figure 19 |

Figure 20 |

Figure 21 |
There are numerous anecdotal reports where Fusarium wilt has occurred in plants grown on land planted to watermelons for the first time or land that had just been cleared of its natural vegetation. How and when the pathogen gets to these fields is more than of just academic interest. Contaminated seed and infected transplants are obvious routes, but the low level of infection observed in commercial watermelon transplants and seed lots likely cannot account for all cases. Likewise, the use of contaminated farm implements (tractors, cultivators, etc.) probably plays a limited role. The question remains as to how and why the pathogen occurs in ‘virgin soil’. Clearly, the pathogen could be introduced during land preparation, but accidental introductions such as this would not be expected to cause wide spread disease. Thus, other mechanisms might be operating. One hypothesis, although there is not much experimental data to support it, is that pathogenic forms somehow evolve from existing nonpathogenic forms. Nonpathogenic strains of F. oxysporum are ubiquitous in soil around the world and are excellent colonizers of plant roots. That they are incapable of causing disease may simply be a function of their inability to penetrate the cortex and enter the xylem. Perhaps in the presence of new hosts some saprophytic strains can develop the ability to penetrate root tissue and invade the xylem causing disease. For a detailed discussion of this and other aspects of the evolutionary biology of F. oxysporum, the reader is referred to the review by Gordon and Martyn.
Disease Management
Fusarium wilts are difficult to manage without durably resistant cultivars; however, there are a number of options that, while they may not be entirely effective alone, can help lessen the severity of the disease.
- Disease-free transplants and seed. Exclusion of the pathogen is one of the best means of disease control. Therefore, transplants and seeds should be obtained from reliable sources and be disease-free. Transplants should be inspected for symptoms of Fusarium wilt (Figure 22) and discarded as appropriate. The reuse of transplant trays is not recommended since they may harbor low levels of FON and thus spread Fusarium wilt to new transplants. Limiting the spread of FON via transplants will help to prevent the introduction of the pathogen into new fields, as well as limit the introduction and dissemination of new races.

Figure 22 |
- Host resistance. Genetic resistance to Fusarium wilt is the best and most economical method of control. However, there is no complete resistance to all races available in any commercial watermelon lines. Many diploid and a few newly released triploid cultivars demonstrate excellent resistance to race 0 and race 1; however, this resistance may break down under high soil populations of the pathogen. There is no high level of resistance to race 2 currently available in commercial watermelon hybrids or cultivars. The advanced PI breeding line, PI-296341-FR, released a number of years ago has excellent resistance to all three races, but incorporating the resistance into commercial types has proven difficult. Additional sources of resistance to race 2 have been reported in other PI lines.
- Crop rotations. Watermelons should never be grown in succession on the same land. Ideally, watermelon should be planted only every 5 to 7 years with non-susceptible plants grown in rotation. While this can help limit the buildup of FON in the soil, chlamydospores are resilient and may remain viable in the soil for many years. Therefore, while successive cropping of watermelons can cause the pathogen to build up to high levels, crop rotation by itself is not likely to control the disease without additional management strategies.
- Soil Fumigation. Moderate reductions in disease severity have been observed with commercial soil treatment products containing methyl bromide, chloropicrin and metam sodium. However, fumigation with these chemicals is seldom completely successful, primarily because of the resistant nature of the chlamydospores, roots that grow from the fumigated portion of the field into non-fumigated, infested portions of the field (below the fumigated zone or between fumigated rows), re-colonization and/or re-infestation of the soil by the pathogen, or because of improper application of the fumigants. In addition, many compounds once approved for soil treatment, including methyl bromide, are being phased out around the world because of health and environmental concerns. Finally, if the pathogen is introduced into a previously fumigated field via infected seeds or transplants, the fumigation would have little effect on control of the disease. In some situations, soil fumigation may not be an economically viable option.
- Soil solarization. Soil solarization is the use of clear plastic mulch placed over fallow soil during the hot months of the year in order to trap the energy from the sun and heat the soil to temperatures that are lethal to the pathogen. It has been used effectively in some locations around the world; however, it is costly and laborious. In addition, disposal of the used plastic is an environmental concern. Soil solarization can be used to lower populations of FON in soil sufficiently to delay the onset of wilt symptoms as well as in reducing disease incidence; however, it does not eliminate the disease and its effectiveness is limited to areas of the world where appropriate climatic conditions exist.
- Grafting. The use of other cucurbit species not susceptible to FON (primarily Cucurbita spp. and Lagenaria spp.) as rootstocks for grafting watermelon has been used successfully to control Fusarium wilt of watermelon. Grafting has been used most commonly in the Asian and Mediterranean basin areas. It has not been used extensively in the United States primarily because it is labor-intensive and costly.
- Biological control. Numerous studies have examined the potential of various types of biological controls for Fusarium wilts in a number of crop plants, including watermelon and muskmelons. While many demonstrate promise in laboratory and greenhouse trials, few have shown significant control at the field level. Examples of some of the approaches investigated are 1) the use of antibiotic-producing soil fungi and bacteria i.e., Gliocladium spp., Trichoderma spp. Pseudomonas spp.; 2) use of non-pathogenic strains of F. oxysporum that compete with pathogenic forms for root colonization (i.e., F.o. strain 47; 3) the use of other formae speciales and races of F. oxysporum to induce resistance in plants to pathogenic forms; and 4) natural or induced soil suppressiveness. The use of cover crops such as hairy vetch as soil amendments (“green manures”) may reduce Fusarium wilt in some location, but the magnitude of the wilt reduction may vary by location. While none of these methods give adequate control in the field, they may be useful when used in combination with other management strategies.
The use of host resistance is still the best method of controlling Fusarium wilt, but because of the widespread presence of race 2, it is no longer a stand-alone management practice in many locations. It is likely that no one technique will result in the complete control of Fusarium wilt of watermelon. However, by combining several different options, adequate control may be achieved.
Significance
Cucurbits (Family Cucurbitaceae) provide humans and animals with numerous edible products. The flesh is an important source of carbohydrates and water for many people of the tropical and semiarid regions of the world. The seeds are rich in oil and protein. Cucurbit production experienced continued growth in the last decade, up 33% worldwide. Approximately 213,000,000 metric tons of watermelons, cucumbers, melons, squashes, and pumpkins were harvested worldwide in 2010. Watermelons represent almost half of the total production (100,000,000 metric tons) and melons (muskmelon, cantaloupe, honeydew) make up another 12% (26,000,000 metric tons). China is the world leader with over 66,000,000 metric tons of watermelon harvested annually, while the United States ranks 5th in world production (1,900,000 metric tons valued at %500 million),. Over 70% of the watermelons produced in the U.S. come from just five states (California, Florida, Texas, Georgia, and Indiana).
Fusarium wilt of watermelon has been an important factor in watermelon production in the U.S. since the late 1800’s. The disease was first described by E. F. Smith in 1894 from South Carolina and was only the second Fusarium wilt disease described (Fusarium wilt of cotton was the first). The disease now occurs in all watermelon growing regions of the world and on every continent except Antarctica. It is the most economically important disease of watermelons throughout the world. While there are no economic loss data due specifically to Fusarium wilt, significant losses continue in many areas of the world, including the U.S. Fusarium wilt causes economic losses in various ways. First, and most obvious, is a direct loss in yield (harvested fruit) because the plant dies. In cases where fields are heavily infested with FON and susceptible varieties are grown, losses may approach 100%. Second, and less obvious but very important, is the loss in marketable yield, i.e. fruit that is formed but cannot be sold because they are too small, misshapen, low in sugars and soluble solids, or may be cracked or sunburned. There also are hidden losses resulting from increased costs associated with having to rogue or replant dead plants, fumigation or other soil treatments, and fuel and labor. Lastly, there are considerable costs associated with renting and preparing new land for production once an existing field becomes unusable because it is infested with FON.
While race 1 of FON is widespread throughout the world, race 2 has a more limited distribution. However race 2 is of great concern because of its ability to attack all current commercial varieties and hybrids. Race 2 was first described in Israel in 1976 and in the U.S. in 1985. It has since been identified in eight states in the U.S. and 12 other countries, including Spain and Turkey. In the US, almost 80% of watermelon production is from states where race 2 has been detected. While the spread of race 2 around the world has been slow, its potential introduction into other major watermelon producing countries i.e., China, Iran, etc. is of concern. Race 3 has only been reported in Maryland, however the potential of its emergence in other states or countries is of great concern.
Selected References
Crall, J.M. 1963. Physiologic specialization in Fusarium oxysporum f.sp. niveum. (Abstr.) Phytopathology 53:873.
Elmstrom, G.W. and D.L. Hopkins. 1981. Resistance of watermelon cultivars to Fusarium wilt. Plant Disease 65:825-827.
Freeman, S., A. Zveibil, and M. Maymon. 2002. Isolation of nonpathogenic mutants of Fusarium oxysporum f. sp. melonis for biological control of Fusarium wilt in cucurbits. Phytopathology 92:164-168.
Gordon, T.R. and R.D. Martyn. 1997. The evolutionary biology of Fusarium oxysporum. Annual Review of Phytopathology 35:111-128.
Hopkins, D.L. and G.W. Elmstrom. 1979. Evaluation of soil fumigants and application methods for the control of Fusarium wilt of watermelon. Plant Disease Reporter 63:1003-1006.
Hopkins, D.L., R.J. Lobinske, and R.P Larkin. 1992. Selection for Fusarium oxysporum f. sp. niveum race 2 in monocultures of watermelon cultivars resistant to Fusarium wilt. Phytopathology 82:290-293.
Jensen, B. D., F.M. Touré, M. Ag Hamattal, F.A. Touré, and A.D. Nantoumé. 2011. Watermelons in the sand of Sahara: Cultivation and use of indigenous landraces in the Tombouctou region of Mali. Ethnobotany Research & Applications 9:151-162.
Keinath, A.P., R.L. Hassell, K.L. Everts and X.G. Zhou. 2010. Cover crops of hybrid common vetch reduce Fusarium wilt of seedless watermelon in the eastern United States. Online. Plant Health Progress. doi: 10.1094/PHP-2010-0914-01-RS
Kim, D.H, R.D. Martyn, and C.W. Magill. 1993. Mitochondrial DNA (mtDNA)-relatedness among formae speciales of Fusarium oxysporum in the Cucurbitaceae. Phytopathology 83:91-97.
Kleczewski, N. and D.S. Egel. 2011. A diagnostic guide for Fusarium wilt of watermelon. Online. Plant Health Progress doi:10.1094/PHP-2011-01-DG.
Larkin, R.P. and D.R. Fravel. 1998. Efficacy of various fungal and bacterial biocontrol organisms for control of Fusarium wilt of tomato. Plant Dis. 82:1022-1028.
Larkin, R.P., D.L. Hopkins, and F.N. Martin. 1990. Vegetative compatibility within Fusarium oxysporum f. sp. niveum and its relationship to virulence, aggressiveness, and race. Canadian Journal of Microbiology 36:352-358.
Harveson, R.M., Kimbrough, J.W. and D.L. Hopkins. 2002. Novel use of a pyrenomycetous mycoparasite for management of Fusarium wilt of watermelon. Plant Disease 86:1025-1030.
Martyn, R.D. 1986. Use of soil solarization to control Fusarium wilt of watermelon. Plant Disease 79:762-766.
Martyn, R.D. 1987. Fusarium oxysporum f. sp. niveum Race 2: A highly aggressive race new to the United Sates. Plant Disease 71:233-236.
Martyn, R.D. 1996. Fusarium wilts. Pages 11-16 in: Compendium of Cucurbit Diseases, T.A. Zitter, D.L. Hopkins, and C.E. Thomas, eds. APS Press, St. Paul, MN.
Martyn, R.D., Biles, C.L. and E.A. Dillard III. 1991. Induced resistance to Fusarium wilt of watermelon under field simulated field conditions. Plant Disease 75:874-877.
Martyn, R.D. and B.D. Bruton. 1989. An initial survey of Fusarium oxysporum f. sp. niveum races in the United States. HortScience 24:696-698.
Martyn R.D. and D.J. Vakalounakis. 2012. Fusarium wilts of greenhouse cucurbits: melon, watermelon, and cucumber. In: M.L. Gullino, J. Katan, and A. Garibaldi (eds). Fusarium Wilts of Greenhouse Vegetable and Ornamental Crops. APS PRESS, St. Paul, MN.
Martyn, R.D. and T.K. Hartz. 1986. Use of soil solarization to control Fusarium wilt of watermelon. Plant Disease 70:762-766.
Martyn, R.D. and R.J. McLaughlin. 1983. Effects of inoculum concentration on the apparent resistance of watermelon to Fusarium oxysporum f. sp. niveum. Plant Disease 67:493-495.</p>
Martyn, R.D. and D. Netzer. 1991. Resistance to races 0, 1, and 2 of Fusarium oxysporum f. sp. niveum in PI-296341-FR (Citrullus sp.). HortScience 26:429-432.
McLaughlin, R. and R.D. Martyn. 1982 Identification and pathogenicity of Fusarium species isolated from surface-disinfected watermelon seed. Journal of Seed Technology 7:97-107.
Rose, S. Parker, M. and Z.K. Punja. 2003. Efficacy of biological and chemical treatments for control of Fusarium root and stem rot on greenhouse cucumber. Plant Disease 87:1462-1470.
Smith, E.F. 1899. Wilt disease of cotton, watermelon, and cowpea (Neocosmospora nov. gen.). U.S. Department of Agriculture, Bull. #17. Washington, D.C.
Zhou, X.G. and K.L. Everts. 2004. Suppression of Fusarium wilt of watermelon by soil amendment with hairy vetch. Plant Disease 88:1357-1365.
